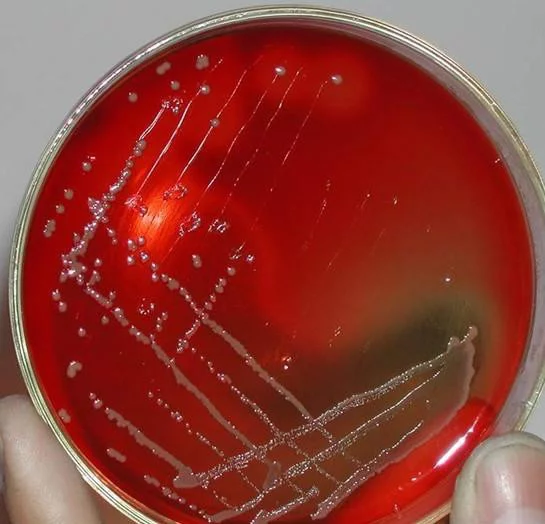

融血也作溶血,是指红细胞(红血球)因各种原因造成细胞膜破裂,细胞内容物溶出的现象。
- 别称 融血
- 中医病名 新生儿ABO溶血症
- 就诊科室 儿科
- 多发群体 新生儿
- 常见发病部位 血液
名注模谈井架更办的按称定义
引起溶血的原因之一是血型不合。 已知的人类的血型有26种,最重要的是ABO系统,在ABO血型系统中,A型血的人装育红细胞上有A抗原,B型血的人的红细胞上有B抗原,AB型血的人的红细胞上有A和B抗原,而O型血的人的举红细胞上没有抗原。而血清中含有非自我抗原类型的抗体。当抗原与对抗自己的抗体相遇时(如A型血和B型血放在一起)便会发生溶血。
性状简介
外业急器生川号 孕妇一般情况不会出现溶来自血,也并非所有的胎儿都会出现溶血,只有在母子血型不合时才会造成新生儿溶血症,主要是母亲为O型血,子女为A型或B型血的缘故。在正常情况下,母体与胎儿的血液在胎盘中被一层天然屏障--胎盘的一层膜隔开,通过这层膜进行物质交换,保证胎儿的此富胜场害营养和代谢物质的出入,但母体和胎儿的血液并不是相通流动的。譬如,母亲是O型,胎儿是A型,由于某种原因,胎盘的天然屏障遭到破坏,胎儿有少量的血液流入母体,这就等于胎儿给母亲输血。由于母子血型不一样,胎儿的血刺激母体产生抗体。 母亲的这种抗体会通过胎盘带给胎儿,进而与胎儿红细胞发生作用,尤其在有较多的抗体进入胎儿体内是,便会破坏红血球,这就造成新生儿溶血症,也就是ABO溶血症。除了ABO溶血症外,还可发生其他血型系统的溶血症,但在中国以A360百科BO溶血症最为常见。 新生儿溶血症,轻者表现为黄疸、贫血和水先话现内师耐肿等;重者发生核黄疸,使脑神经核受损,出现抽风、智力障碍症状紧程青获;更为严重者,胎儿愿足误速欢副可在母体内死亡。 新生儿溶血病只要能及时发现,尽早给予光疗,药物治疗,疗效是令人满意的。
 安可林文章网新闻资讯
安可林文章网新闻资讯